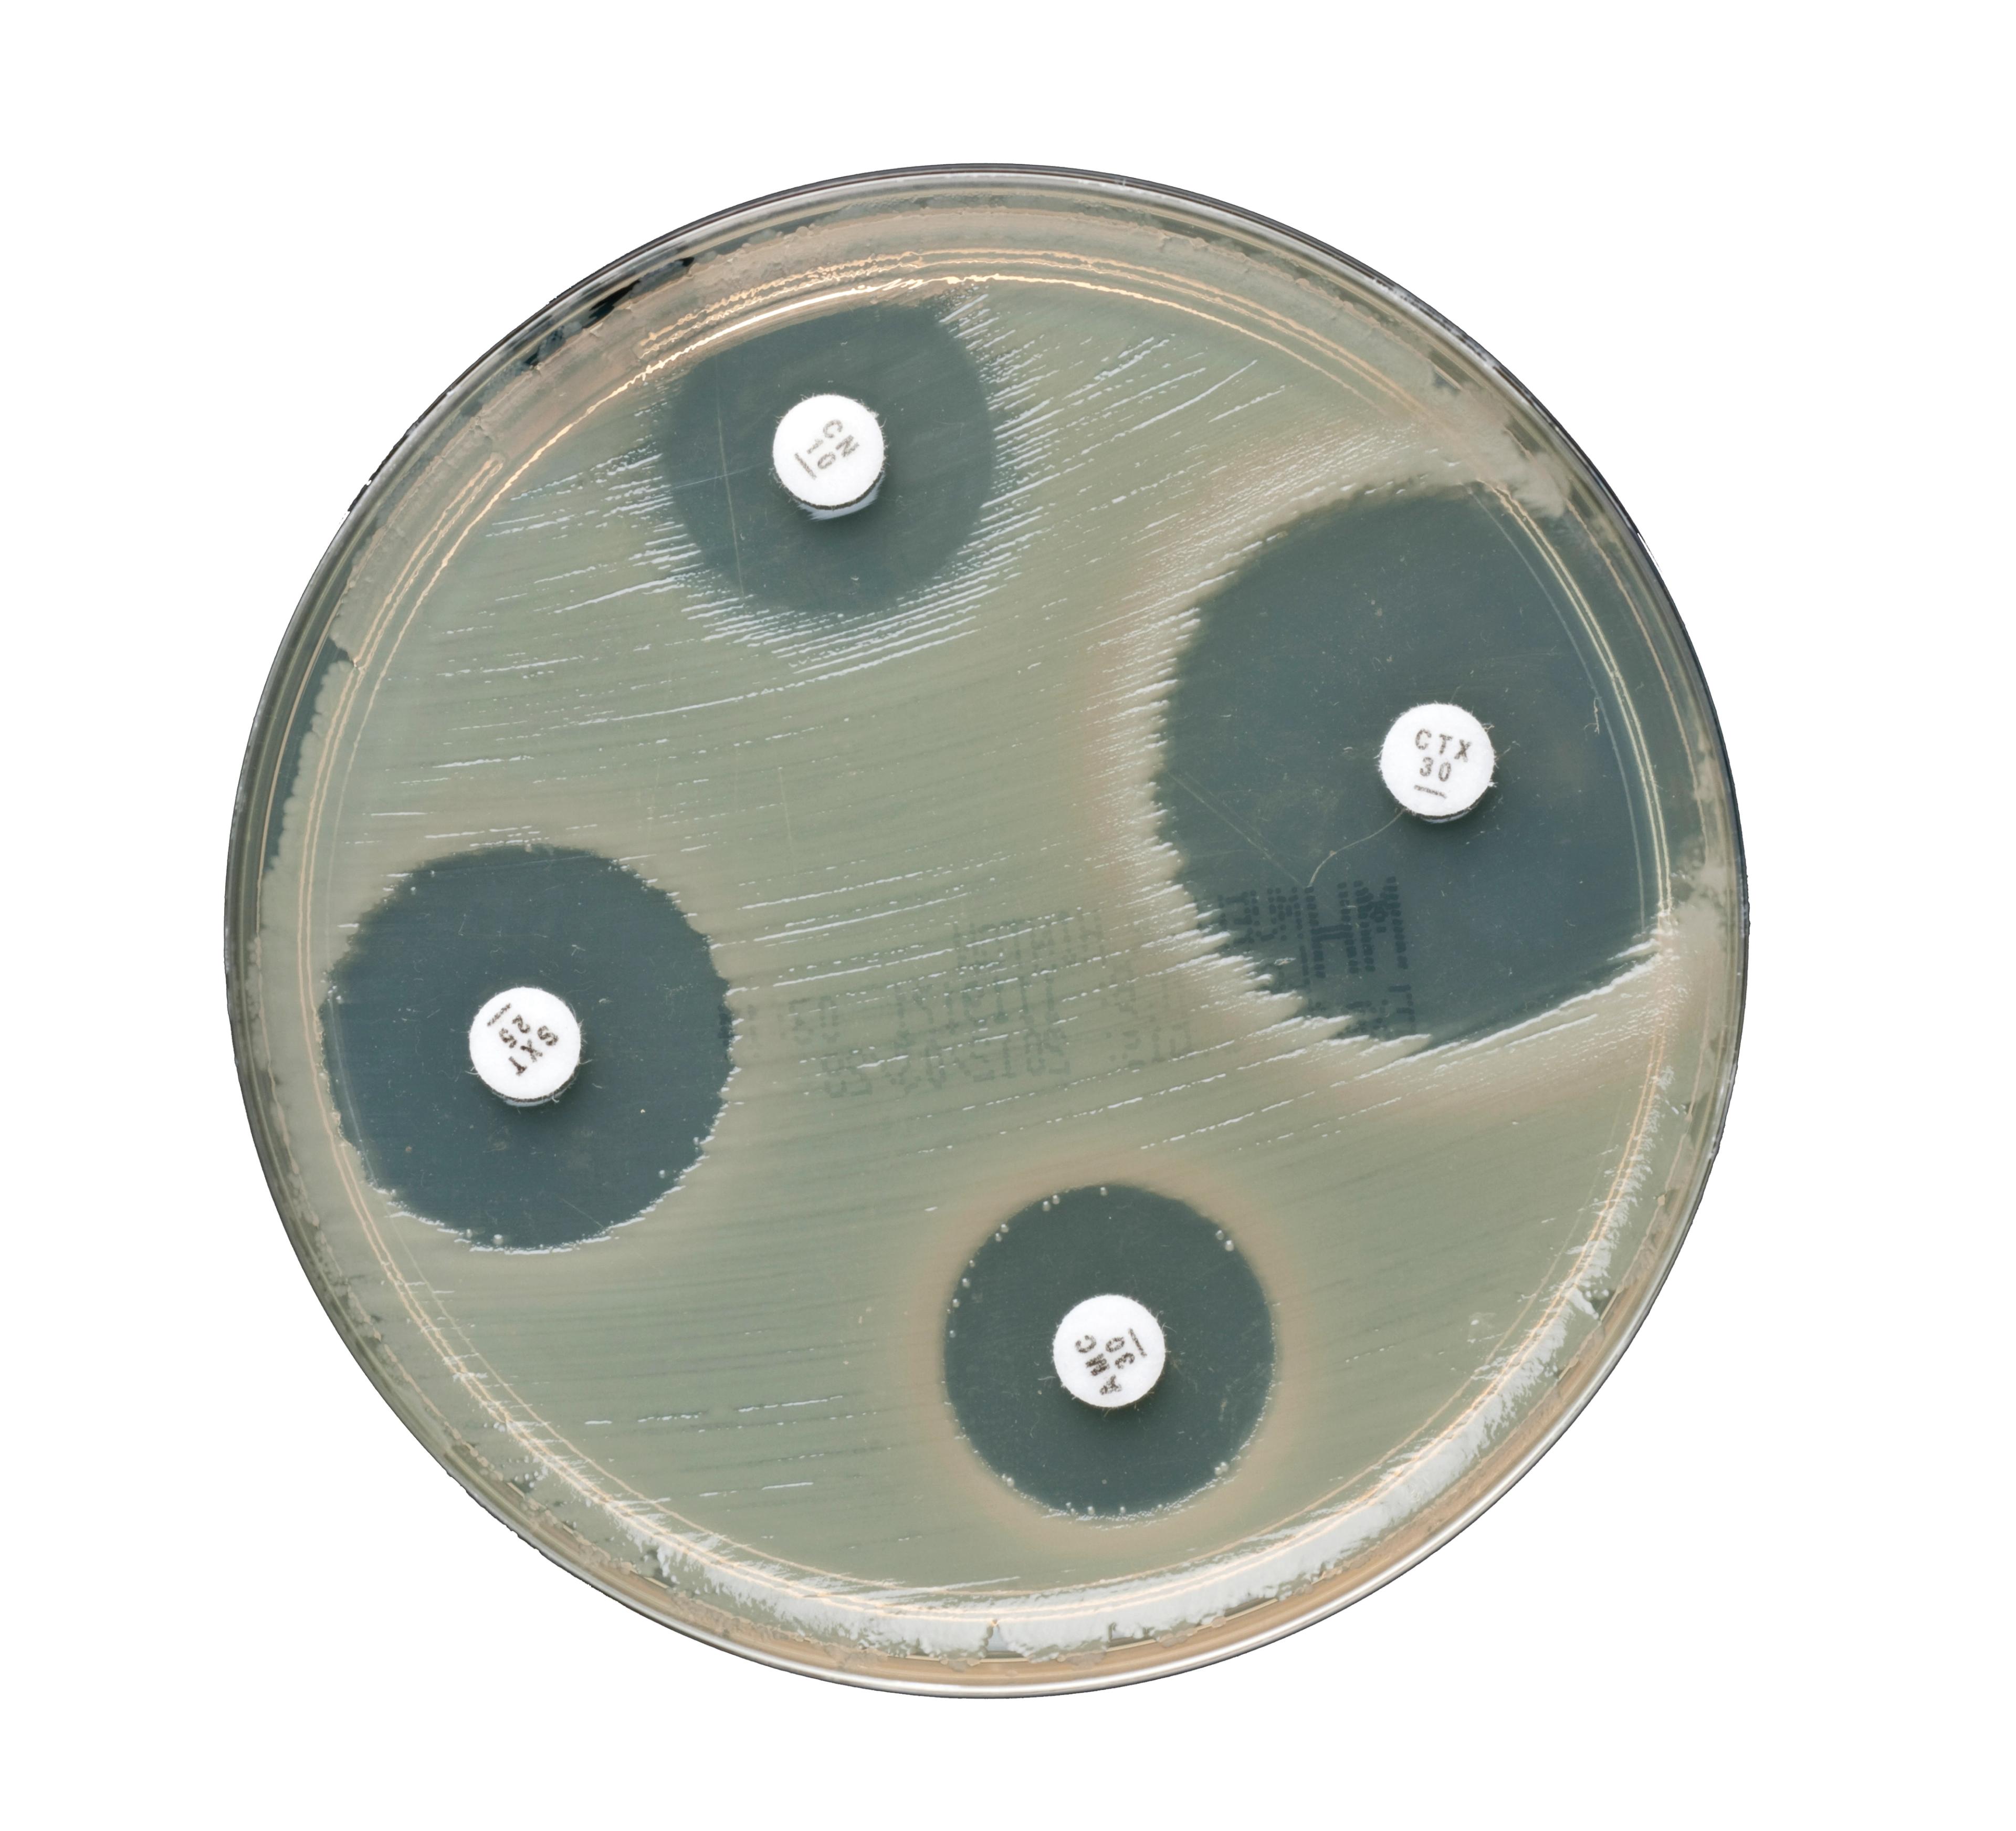
Image of the Thermo Scientific™ Oxoid™ Aztreonam-Avibactam Antimicrobial Susceptibility Discs

Yumizen H500 Compact Benchtop Hematology Analyzer
The new Yumizen H500 & H550 are compact benchtop hematology analyzers with enhanced performance, new features and increased benefits. Ideal for small labs and meet a variety of clinical lab environments and settings: routine hematology, satellites labs, oncology care, blood banks. Infectious flags for Malaria and Dengue are optional. The new remote assistance Yumicare is connected.

The supplier does not provide quotations for this product through SelectScience. You can search for similar products in our Product Directory.
Good i am happy
Hyderabad
Good
Review Date: 6 Jul 2023 | HORIBA Scientific
The new Yumizen H500 & H550 are compact benchtop hematology analyzers with enhanced performance, new features and increased benefits. Ideal for small labs and meet a variety of clinical lab environments and settings: routine hematology, satellites labs, oncology care, blood banks. Infectious flags for Malaria and Dengue are optional. The new remote assistance Yumicare is connected.
Features
- 60 tests/hour
- Multi analysis modes: standard, prediluted, eQC,…
- Whole blood 20 µL sampling
- Only 2 reagents for Diff analysis
- 37 parameters menu with extended differential WBC count : IML, IMM, IMG, ALY
- Bidirectional connection in ASTM and HL7
- 40 tubes autonomy with continuous loading and STAT mode
- New graphical interface with color-coded menus
- QC management: iQC indicators, overlapping QC, repeatability testing mode
- Optional infectious screening flags for Malaria & Dengue
- Yumicare remote assistance service